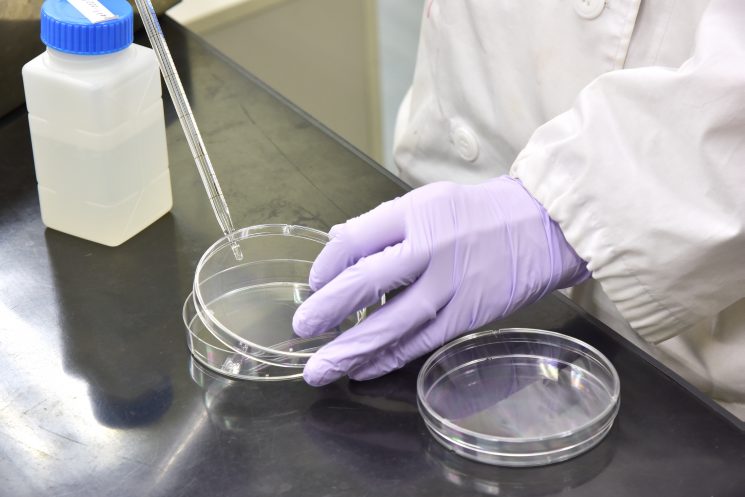

飲用井戸検査
- マスクフィットテスト測定
- 河川水・湖沼水検査
- 地下水検査
- 飲用井戸検査
- 飲料水検査
- 食品製造用水質検査
- プール水・浴槽水検査
- 簡易専用水道法定検査
- 各種水利用の水質等
- 事業所排水検査
- ビル衛生管理法
- 温泉分析
- 浄水場管理
- 給水用具・水道用資機材等の浸出性能試験
- 水生生物調査
- 環境ホルモン分析
- 土壌分析・建設発生土
- 燃え殻・汚泥分析
- 底質検査
- セメント系固化剤改良土分析
- 油汚染ガイドライン
- 材料・製品分析
- 異物検査
- ばい煙測定
- 排出ガス中のVOC測定
- ダイオキシン類
- 臭気測定
- 環境大気測定
- 作業環境測定
- アスベスト検査
- 騒音・振動測定
- シックスクール・シックハウス
- 放射能測定
- 医薬品分析
- 食品等の試験
- PCB分析
- 橋梁塗料分析
- 環境アセスメント・生活アセスメント
- 工場や施設に係る法令調査
- ISO9001取得支援・ISO14001取得支援
- エコアクション21取得支援
- 福祉サービス第三者評価